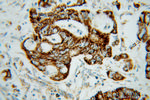
MRPL12 Antibody in Immunohistochemistry (Paraffin) (IHC (P))

Search
Proteintech
MRPL12 Polyclonal Antibody
{{$productOrderCtrl.translations['antibody.pdp.commerceCard.promotion.promotions']}}
{{$productOrderCtrl.translations['antibody.pdp.commerceCard.promotion.viewpromo']}}
{{$productOrderCtrl.translations['antibody.pdp.commerceCard.promotion.promocode']}}: {{promo.promoCode}} {{promo.promoTitle}} {{promo.promoDescription}}. {{$productOrderCtrl.translations['antibody.pdp.commerceCard.promotion.learnmore']}}

Please note: We are reviewing Western blot images included in the antibody testing data in our catalog, including those provided by third parties. Unless expressly labeled or annotated as “raw-unedited”, Western blot images included in the antibody testing data in our catalog may have been edited, optimized or otherwise adjusted for presentation.
产品信息
14795-1-AP
种属反应
已发表种属
宿主/亚型
分类
类型
抗原
偶联物
形式
浓度
规格
纯化类型
保存液
内含物
保存条件
运输条件
产品详细信息
The antibody reacts specifically with 21 kDa MRPL12 protein.
Immunogen sequence: MLPAAARPL WGPCLGLRAA AFRLARRQVP CVCAVRHMRS SGHQRCEALA GAPLDNAPKE YPPKIQQLVQ DIASLTLLEI SDLNELLKKT LKIQDVGLVP MGGVMSGAVP AAAAQEAVEE DIPIAKERTH FTVRLTEAKP VDKVKLIKEI KNYIQGINLV QAKKLVESLP QEIKANVAKA EAEKIKAALE AVGGTVVLE (1-198 aa encoded by BC002344 )
靶标信息
MRPL12 (mitochondrial ribosomal protein L12), also referred to as 5c5-2, L12mt, MRPL7 or RPML12, is a mammalian mitochondrial ribosomal protein that is involved in protein synthesis within the mitochondrion. MRPL12 is enhanced in growth-stimulated cells as a result of transcriptional activation, suggesting that it may function as a translational regulator of mitochondrial mRNAs. Impairment of MRPL12 leads to reduction in cell growth rate, decreased mitochondrial ATP production and abolition of mitochondrial oxidative phosphorylation. MRPL12 is cleaved during its translocation across the mitochondrial membrane and it exists as dimers that bind the large ribosomal subunit. MRPL12 is 198 amino acids in length, belongs to the ribosomal protein L12P family and is highly expressed in the colon.
仅用于科研。不用于诊断过程。未经明确授权不得转售。
生物信息学
蛋白别名: 39S ribosomal protein L12, mitochondrial; 5c5-2; FLJ60124; L12mt; Large ribosomal subunit protein bL12m; MGC8610; mitochondrial large ribosomal subunit protein bL12m; MRP-L12; ribosomal protein, mitochondrial, L12
基因别名: 0610034O11Rik; 1500031N16Rik; 5c5-2; bL12m; L12mt; MRP-L12; MRP-L31/34; MRPL12; MRPL7; MRPL7/L12; Rpm12; RPML12
UniProt ID: (Mouse) Q9DB15
Entrez Gene ID: (Human) 6182, (Mouse) 56282, (Rat) 303746




